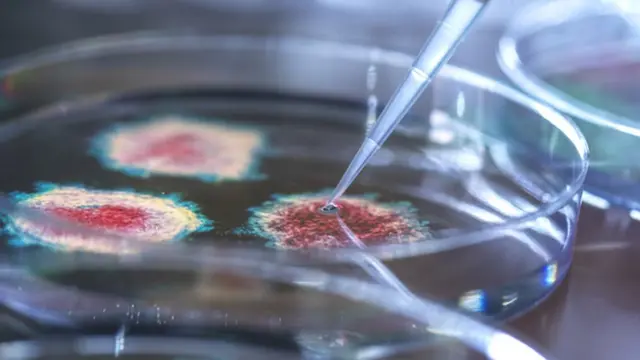
கொரோனா வைரஸ் கோப்புப் படம்

ஓமிக்ரான் கொரோனா திரிபை 'கவலைக்குரிய திரிபு' என அறிவித்த உலக சுகாதார அமைப்பு - B.1.1.529

பட மூலாதாரம், Getty Images
B.1.1.529 என்றழைக்கப்படும் 50 பிறழ்வுகளைக் கொண்ட இந்த புதிய கொரோனா திரிபுக்கு, உலக சுகாதார அமைப்பு வெள்ளிக்கிழமை ஒமிக்ரான் (Omicron) ஒரு புதிய கிரேக்க பெயரை சூட்டி உள்ளது.
மேலும் இத்திரிபை 'கவலைக்குரிய திரிபு' (Variant of Concern) என வகைப்படுத்தி உள்ளது உலக சுகாதார அமைப்பு. ஆரம்ப கால ஆதாரங்கள் அடிப்படையில் இத்திரிபு வேகமாக பரவும் அபாயம் கொண்டதாக பரிந்துரைக்கிறது.
இந்தத் திரிபில் உள்ள அனைத்து மரபணு பிறழ்வுகளும் ஆபத்தானவை இல்லை என்றாலும், சில பிறழ்வுகள் காரணமாக இதற்கு பரவும் தன்மை, தொற்றும் தன்மை, உடலில் அதிகமான பாதிப்பை உண்டாக்கும் தன்மை ஆகியவற்றின் இருப்பதால் இது கவலைக்குரிய திரிபு என்று வகைப்படுத்தப்பட்டுள்ளது.
இந்தத் திரிபின் இயல்பு காரணமாக ஏற்கனவே கொரோனா தொற்று உண்டானவர்களுக்கும் மீண்டும் நோய் தொற்றுவதற்கான அபாயம் உண்டாகியுள்ளது.
நவம்பர் 24 அன்று முதலில் தென்னாப்பிரிக்காவில் கண்டறியப்பட்ட இந்தத் திரிபு ஹாங்காங், பெல்ஜியம், போட்ஸ்வானா, இஸ்ரேல் ஆகிய நாடுகளில் இருப்பது இதுவரை உறுதியாகியுள்ளது.

பட மூலாதாரம், Getty Images
தோற்கடிக்க முடியாத நோயாளியின் உடலிலிருந்து...
"புதிய கொரோனா திரிபில் வழக்கத்துக்கு மாறாக பல்வேறு பிறழ்வுகள் உள்ளன. இது மற்ற கொரோனா திரிபுகளிலிருந்து மிகவும் வேறுபட்டதாக உள்ளது" என தென்னாப்பிரிக்காவில் உள்ள சென்டர் ஃபார் எபிடமிக் ரெஸ்பான்ஸ் அண்ட் இன்னொவேஷன் என்கிற அமைப்பின் இயக்குநர் பேராசிரியர் டுளியோ டி ஒலிவெரியா கூறினார்.
இந்த கொரோனா திரிபு எங்களை ஆச்சரியத்படுத்துகிறது. இத்திரிபு, அதன் பரிணாம வளர்ச்சியில் மிகப் பெரும் பாய்ச்சலை கண்டுள்ளது. நாங்கள் எதிர்பார்த்ததை விட அதிக அளவிலான பிறழ்வுகளை கொண்டுள்ளது என்றும் கூறினார்.
இந்த புதிய கொரோனா வைரஸ் திரிபில் 50 மரபணு பிறழ்வுகள் உள்ளன என்றும், ஸ்பைக் புரோட்டின் இடையில் 30க்கும் மேற்பட்ட பிறழ்வுகள் இருப்பதாகவும் ஒரு பத்திரிகையாளர் சந்திப்பில் குறிப்பிட்டார் பேராசிரியர் டுளியோ டி ஒலிவெரியா.
கொரோனா தடுப்பூசிகள் இந்த ஸ்பைக் புரத இழையைத்தான் இலக்கு வைக்கின்றன. அதேபோல மனிதர்களின் உடலுக்குள் ஊடுறுவ கொரோனா வைரஸ் இந்த ஸ்பைக் புரத இழையைத்தான் பயன்படுத்துகின்றது.
மனிதர்களின் உடலோடு முதலில் தொடர்பு கொள்ளும் ரெசப்டாரில் 10 பிறழ்வுகள் உள்ளன. உலகை உலுக்கிய கொரோனா வைரஸின் டெல்டா திரிபிலேயே ரெசப்டார்களில் இரண்டு பிறழ்வுகள் மட்டுமே இருந்தன.
கொரோனா வைரஸை தோற்கடிக்க முடியாத ஒரு நோயாளியின் உடலிலிருந்து இத்தனை அதிக பிறழ்வுகள் ஏற்பட்டிருக்கலாம்.
பட மூலாதாரம், Getty Images
பொதுவாக அதிக பிறழ்வுகள் என்றாலே ஆபத்தானவை என்று பொருள் அல்ல, அந்த பிறழ்வுகள் என்ன செய்கின்றன என்பதை அறிந்து கொள்வது அவசியம்.
தென்னாப்பிரிக்காவின் கெளடெங் மாகாணத்தில் 77 பேரும், போட்ஸ்வானாவில் நான்கு பேரும், ஹாங்காங்கில் ஒருவரும் இத்திரிபால் பாதிக்கப்பட்டிருக்கின்றனர். அனைவரும் தென்னாப்பிரிக்கா உடன் பயணத் தொடர்புடையவர்களாக உள்ளனர்.
இத்திரிபு இன்னும் பரவலாக பரவியிருப்பதற்கான குறிப்புகள் உள்ளன. இந்த திரிபை முழுமையான மரபணு சோதனை செய்யாமல், நிலையான பரிசோதனைகளிலேயே (Standard Test) இந்த திரிபை கண்டுபிடிக்க முடியும்.
இச்சோதனையில் கெளடெங் மாகாணத்தில் கொரோனாவால் பாதிக்கப்பட்டு இருப்பவர்களில் 90% பேர் இத்திரிபால் பாதிக்கப்பட்டிருக்கலாம் என்றும், மற்ற மாகாணங்களிலும் இத்திரிபு பரவியிருக்கலாம் என்றும் இச்சோதனை பரிந்துரைக்கிறது.
டெல்டா திரிபை விட இத்திரிபு அதிவேகமாக பரவக் கூடியதா, அதன் தீவிரத்தன்மை என்ன, தடுப்பூசிகளால் கிடைக்கும் பாதுகாப்பை இத்திரிபால் எந்த அளவுக்கு கடக்க முடியும் என்பதை எல்லாம் அச்சோதனை நமக்கு வெளிப்படுத்தாது.
மேலும், அதிகம் தடுப்பூசி செலுத்திக் கொண்டுள்ள நாடுகளில் இத்திரிபு எப்படி பரவும் என்பது குறித்த தகவல்களையும் வெளிப்படுத்தாது. தென்னாப்பிரிகாவில் 24% பேர் மட்டுமே முழுமையாக கொரோனா தடுப்பூசி செலுத்திக் கொண்டனர் என்றாலும், அந்நாட்டில் பலருக்கும் கொரோனா தொற்று ஏற்பட்டது என்பது குறிப்பிடத்தக்கது.
பிற செய்திகள்:
- டைனோசர்கள் குறித்த கட்டுக்கதைகளும் அதன் உண்மைகளும்
- இந்தியா - இலங்கை உடன்படிக்கை ஏற்பட்டால் தாயகம் திரும்ப விரும்பும் அகதிகள் - நிபந்தனை என்ன?
- விவசாயிகள் போராட்டம்: ஒவைசியை தாக்கும் திகைத், தேர்தலை முன்னிட்டு இயக்கத்தில் பிளவா?
- மாணவிகளுக்கு எதிரான பாலியல் குற்றங்கள்: தமிழ்நாடு அரசின் 14417 உதவி எண் நிலை என்ன?
- காஷ்மீர் பூஞ்ச் என்கவுன்டர்: இறந்த படையினரின் குடும்பத்தினர் எழுப்பும் விடையில்லா கேள்விகள்
- காணாமல் போயிருந்த முன்னாள் மும்பை போலீஸ் ஆணையர் பரம்வீர் சிங் மீண்டும் தோன்றினார்
சமூக ஊடகங்களில் பிபிசி தமிழ் :
- ஃபேஸ்புக் : பிபிசி தமிழ் ஃபேஸ்புக்
- டிவிட்டர் : பிபிசி தமிழ் ட்விட்டர்
- இன்ஸ்டாகிராம் : பிபிசி தமிழ் இன்ஸ்டாகிராம்
- யு டியூப் : பிபிசி தமிழ் யுடியூப்












